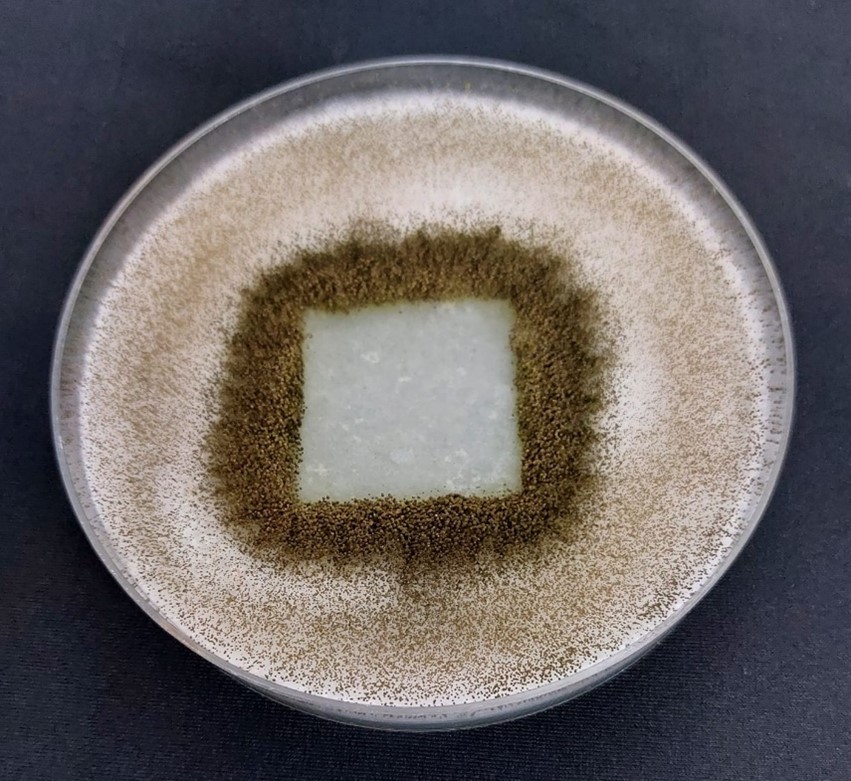
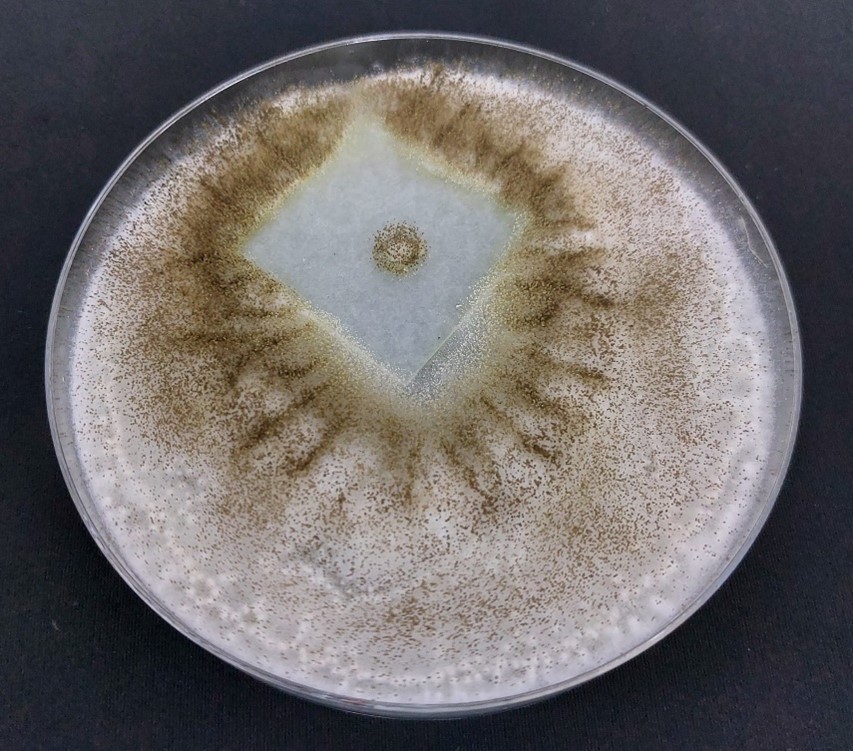

ในอดีต มีความนิยมนำไม้มาใช้เป็นวัสดุในการก่อสร้างอาคาร ที่พักอาศัยและข้าวของเครื่องใช้ต่างๆ กันอย่างแพร่หลาย แต่เป็นที่ทราบกันดีว่าเมื่อผ่านการใช้งานไปสักระยะหนึ่ง เนื้อไม้มักจะมีการเสื่อมสภาพจากหลายๆ ปัจจัย
และหนึ่งในสาเหตุหลักก็คือน้ำและความชื้น ซึ่งส่งเสริมให้เชื้อราสามารถเจริญเติบโตบนเนื้อไม้ได้ ทำให้ไม้มีตำหนิด่างดำไม่สวยงามและอาจผุกร่อนหากปล่อยไว้เป็นเวลานาน
จึงได้มีการคิดค้นพัฒนาผลิตภัณฑ์สีย้อมเคลือบไม้ ออกมาใช้เพื่อเป็นปราการด่านแรกในการปกป้องเนื้อไม้จากปัจจัยความเสื่อมสภาพต่างๆ รวมถึงการเกิดเชื้อราด้วย
แต่จะทราบได้อย่างไรว่าผลิตภัณฑ์สีย้อมเคลือบไม้สูตรใด มีความทนเชื้อราได้จริง จึงต้องอาศัยทำการทดสอบความทนเชื้อราของสีย้อมเคลือบไม้เพื่อให้ได้คำตอบที่แน่ชัด โดยมีมาตรฐานผลิตภัณฑ์และมาตรฐานการทดสอบที่เกี่ยวข้องดังต่อไปนี้
1. มาตรฐานผลิตภัณฑ์ มอก. 1513-2563 สีย้อมเคลือบไม้ชนิดตัวทำละลาย (SOVENT-BASED WOOD STAIN COATING)ข้อ 5.9 ความทนเชื้อรา โดยเกณฑ์กำหนด จะต้องไม่เกิดเชื้อรา ให้ทำการทดสอบตามมาตรฐาน มอก. 285 เล่ม 21
2. มาตรฐานการทดสอบ มอก. 285 เล่ม 21-2563 วิธีทดสอบสี วาร์นิช และวัสดุที่เกี่ยวข้องเล่ม 21 การทดสอบความทนเชื้อรา (TEST METHOD FOR PAINS VARNISHED AND RELATED MATERIALS PART 21 FUNGAL RESISTANCE TEST)
โดยทำการทดสอบกับสารละลายสปอร์ผสม (Mixed spore suspension) ของเชื้อรา 2 ชนิด ได้แก่
1. เชื้อรา Cladosporium cladosporioidesเป็นเชื้อราที่มีสีเข้ม พบทั่วไปในสิ่งแวดล้อม เป็นเชื้อราที่พบมากที่สุดชนิดหนึ่งในอากาศ สามารถเจริญเติบโตได้ในสภาวะแห้งแล้งและอุณหภูมิต่ำ
2. เชื้อรา Aspergillus nigerเป็นเชื้อราที่พบได้ทั้งในรูปของการสืบพันธุ์แบบไม่อาศัยเพศและแบบอาศัยเพศ การสืบพันธุ์แบบไม่อาศัยเพศจะสร้างสปอร์แบบไม่อาศัยเพศ เรียกว่า conidia พบทั่วไปในสิ่งแวดล้อม